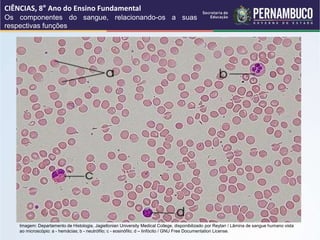
CIÊNCIAS, 8° Ano do Ensino Fundamental
Os componentes do sangue, relacionando-os a suas
respectivas funções
Imagem: Departamento de Histologia, Jagiellonian University Medical College, disponibilizado por Reytan / Lâmina de sangue humano vista
ao microscópio: a - hemácias; b - neutrófilo; c - eosinófilo; d – linfócito / GNU Free Documentation License.

O documento descreve os principais componentes do sangue e suas funções, incluindo o plasma, hemácias, leucócitos e plaquetas. Discorre sobre como o plasma transporta nutrientes, gases e hormônios, enquanto as hemácias transportam oxigênio e os leucócitos auxiliam na imunidade e defesa do corpo. Também explica que as plaquetas promovem a coagulação do sangue.